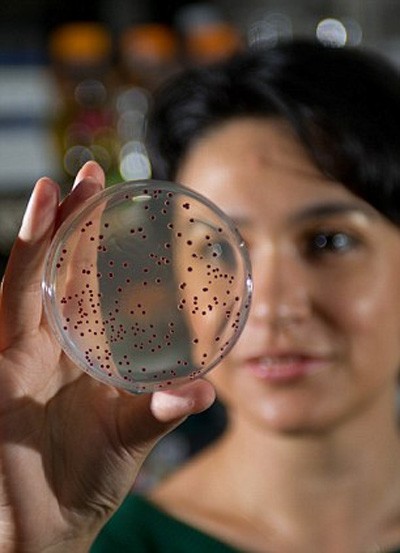

Một vi khuẩn mới… 500 triệu tuổi đã được mang trở lại thế gian trong một cuộc thí nghiệm gợi nhớ lại sự tạo ra khủng long trong phim Công viên Kỷ Jura.
Một vi khuẩn mới… 500 triệu tuổi đã được mang trở lại thế gian trong một cuộc thí nghiệm gợi nhớ lại sự tạo ra khủng long trong phim Công viên Kỷ Jura.
Các nghà nghiên cứu của Viện Công nghệ Georgia (Mỹ) đã làm sống lại một gien có từ 500 triệu năm trước và cấy nó vào vi khuẩn E Coli hiện đại.
Vi khuẩn “Frankenstein” này nhanh chóng phát triển mạnh. Trong phòng thí nghiệm, hiện chúng đã trải qua hơn 1.000 thế hệ.
Vi khuẩn cổ đại được cấy trong phòng thí nghiệm - Ảnh: Georgia Tech
Các nhà khoa học hy vọng có thể xác định liệu vi khuẩn “cổ đại” sẽ tiến hóa giống như trước khi tuyệt diệt, hoặc sẽ phát triển thành một cơ thể mới và khác biệt để phù hợp với một tương lai mới.
“Điều này gần giống như chúng ta có thể quay lại từ đầu và xem lại một cuốn băng cuộc sống của phân tử,” theo esciencenews.com dẫn lời nghiên cứu sinh Betül Kaçar của Viện Công nghệ Georgia.
Vi khuẩn dường như chỉ tồn tại trong ảo tưởng đã đột biến nhanh chóng, với một số trở nên mạnh và khỏe hơn vi khuẩn ngày nay, theo báo cáo của nhóm nghiên cứu trước hội nghị Khoa học Sinh học Vũ trụ quốc tế của NASA
Chuyên gia Kaçar cho rằng quá trình trên có thể cho phép giới khoa học giải quyết một số thắc mắc còn tồn đọng lâu nay về sự tiến hóa và phân tử trong sinh học.
Một trong số đó là liệu lịch sử của một sinh vật có làm hạn chế tương lai của nó không, và liệu tiến hóa luôn dẫn đến một kết cục đơn nhất hay có vô số giải pháp cho một vấn đề?
Phi Yến
Theo Thanhnien